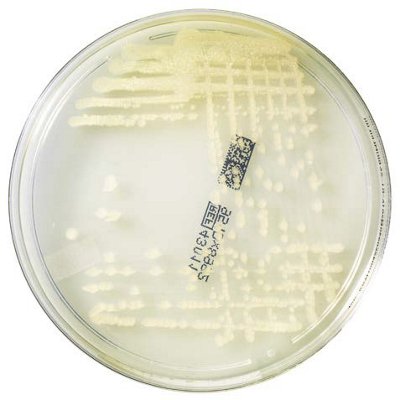
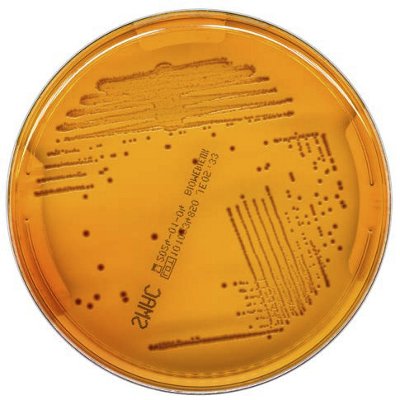

Conventional Media
An extensive range of high quality conventional agar with selective and differential media for daily routine
Put your confidence in bioMérieux, with High-Quality Culture Media Backed by 60+ Years of Leadership and expertise.
Disclaimer: Product availability varies by country. Please consult your local bioMérieux representative for product availability in your country.

- conventional media
- Overview
- Catalog
- Add-on Products
- Resources
Overview
The extensive range of pre-poured conventional agar culture media offers high-quality nutritive, selective and differential media for daily routine.
- Quality paired with cost-effectiveness. Flexible for all lab sizes and situations.
- Some media are available in different formats (dehydrated, tube, bottle).
- Certificate of Compatibility with complementary bioMérieux instruments and reagents.
CULTURE OF QUALITY BACKED BY CERTIFICATES AND VALIDATIONS FOR CULTURE MEDIA
Quality control (QC) and a secured supply chain processes: confidence during the entire value chain
- Shelf-life and storage temperature: The stability of many of our culture media is validated with thermal shock validation in a reallife lab situation. It allows storage of 2-4 weeks at room temperature (15-25°C) in daily routine use.
- Thermal shock validation: Possible temperature variation accounts during delivery/transportation. Our media are validated using thermal shock simulation sequences. It guarantees the best performance regardless of the shipment conditions.
- The hidden part of the quality certificate: Guarantees consistent product quality for batch-to-batch reproducibility and enables your lab to avoid biological controls, e.g. fertility with QC strains and batch-to-batch comparison, before use.
- High confidence - proven performance: Instructions for Use (IFU) can be used as proof to mitigate risk analysis within your quality management system. Detailed peformances limit the need for heavy validation with biological testing.
- Secured supply chain process: A robust supply chain process guarantees the best delivery times, with an optimized residual shelf life at the customer site for each culture media to guarantee lab staff satisfaction.
- Fast lab staff training: Easy qualification management with reading guides and tutorials.
Unique certificates of compatibility
bioMérieux verifies the compatibility of its culture media with its reagents and systems and issues a validated Certificate of Compatibility, allowing you to gain confidence in compatibility while lightening your workload. You can view and download these certificates at resourcecenter.biomerieux.com.
Catalog
Conventional Media
Blood Agar Range to support growth of fastidious organisms
High quality blood agar for standardized hemolysis and easy reading for most bacteria
%20agar?qlt=85&ts=1710867131758&dpr=off)
Media for AST - ETEST® strips
ETEST® ready-to-use reagent strips to determine on-scale MIC
bioMérieux media for antimicrobial susceptibility testing (AST) are validated for use with ETEST® strips. With a predefined, stable gradient of 15 antimicrobial concentrations, ETEST® provides MIC with greater precision for challenging situations (critically ill patients, fastidious organsims, MDRO’s, etc..).
ETEST® is compliant with CLSI® (Clinical and Laboratory Standards Institute Inc.) & EUCAST® (European Committee on Antimicrobial Susceptibility Testing) guidelines.
OTHER MEDIA FOR AST
Add-on Products
Atmosphere Generators for Fastidious Bacteria
GENbag and GENbox facilitate culture of bacteria that require anaerobic, microaerophilic or capnophilic atmospheres. This bacterial growth can be observed without opening either system.
GENbag
FOR INCUBATING FROM 1 TO 5 PLATES
NOTE: each GENbag kit contains 20 bags + 20 gaz generators + 2 clip seals.

GENbox
FOR INCUBATING MULTIPLE PLATES
NOTE: each GENbox kit contains 10 gaz generators.

?qlt=85&ts=1709556854983&dpr=off)

?qlt=85&ts=1709559264495&dpr=off)
?qlt=85&ts=1710846069082&dpr=off)

%20MEDIUM?qlt=85&ts=1709559454199&dpr=off)


















